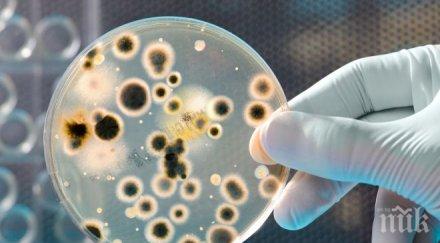
неочаквани източници микроби

ГОРЕЩО
ПОТОП! Частично бедствено положение в община Вълчи дол заради порой
СПРЕТЕ СЕ ВЕЧЕ! Мрежата завря от спекулации със смъртта на Любен Дилов-син - забъркаха и КОВИД ваксините
Откриха труп на мъж в Кърджали
ДБ СКАНДАЛНО опитва да прокара ЛГБТ пропаганда в училищата, маскира я като "езикова грамотност"
КЪРВАВ ЕКШЪН В МОНТАНА! Разбиха с брадва главата на 17-годишно момче

Диета със сланина стана хит в нета, създателят й е свалил 70 кг
80208
на 13.11.2017

Не сдържайте емоциите, днес е ден за любов
11536
на 01.10.2017

Млада майка от Варна се бори за живота си!
12314
на 29.09.2017

Тато питал БАН сурвака ли се на Нова година
41216
на 09.01.2017

Столичанка плати 2 бона откуп за откраднатите си кученца
7652
на 03.11.2016

Жена повика линейка, болели я краката от дълъг шопинг
15056
на 04.09.2016

Час обикаляне пести 5 лева гръцка такса
7724
на 07.07.2016
5 неочаквани източници на микроби
24870
на 31.05.2016

8 г. затвор за мъж, убил с нож жена край Бургас
9577
на 13.04.2016

Ето как пазаруват зодиите
28709
на 19.03.2016
ПОСЛЕДНИ НОВИНИ

Стрелба в заведение в Кьолн
1443
преди 16 минути

Топ ползи за здравето от малините - суперхрана за тялото ни
4712
преди 35 минути

ПОТОП! Частично бедствено положение в община Вълчи дол заради порой
7451
преди 41 минути

Откриха труп на мъж в Кърджали
6433
преди 48 минути

19-годишен загина при катастрофа край Гоце Делчев
6748
преди 51 минути

Българите са първи в ЕС по получаване на социални помощи в Германия
4735
преди 56 минути

Ваучерите за храна може да бъдат спрени
6132
преди 1 часа
НАЙ-ЧЕТЕНИ

Мрежата се ВЗРИВИ от ГНЯВ: Дано умрете цялата гейска група "калашниците"!
509484
преди 21 часа

ОТ ПОСЛЕДНИТЕ МИНУТИ: Тръмп праща ТОЗИ ЧОВЕК за посланик у нас
374196
на 02.06.2026

































